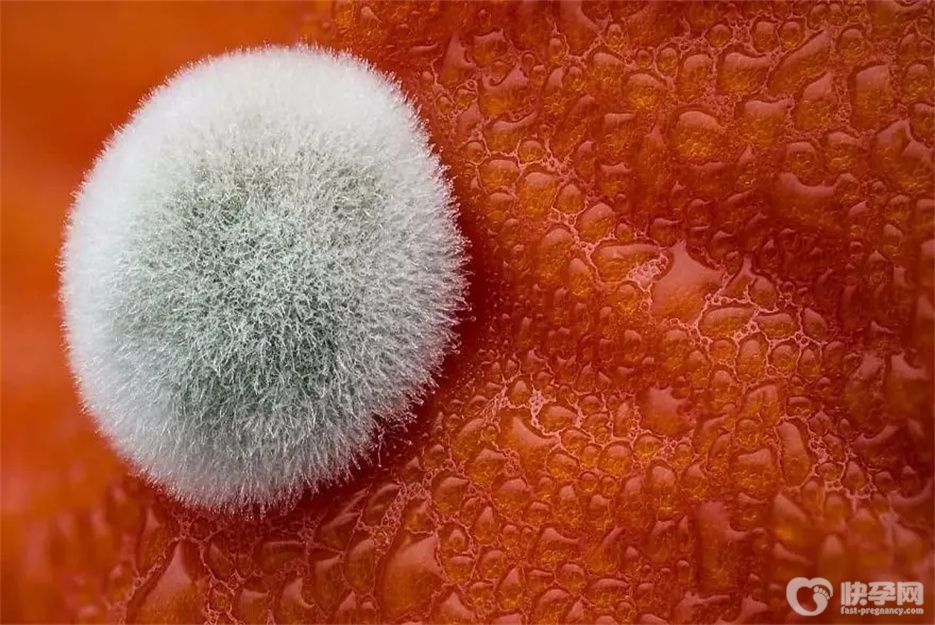

盘点霉菌最怕的三种东西,早知晓早受益
- 备孕育儿
- 2026-01-01 10:18
女性感染阴道和霉菌是很常见的。治疗的方法有很多,但是最好最方便的方法就是通过饮食来调理。下面就来带大家了解下霉菌最怕三种东西有哪些。
霉菌最怕三种东西
1、高温环境
霉菌怕高温。当霉菌处于60度以上的高温环境时,就会死亡。霉菌在温暖的环境中会大量繁殖,所以我们在生活中清洗内衣时,可以用高于60度的热水清洗,然后在阳光下暴晒,有助于预防霉菌性阴道炎的发生。
2、酸奶
酸奶建议平时适当食用。确实有改善霉菌炎症的作用。因为酸奶的摄入可以使有益菌在一定数量上繁殖,同时对生长速度也有一定的加速作用,对有害菌有很好的抵抗作用,所以也可以达到治疗和改善疾病的效果。而且经常吃酸奶还可以帮助缓解便秘,让你远离很多烦恼。
3、新鲜蔬菜
绿色的新鲜蔬菜真的是改善霉菌炎症的必备品,尤其是苋菜,富含膳食纤维,对小肠和大肠都有一定的益处,还能起到一定的清热益气的作用。除了苋菜,扁豆也是可以的,因为扁豆有很好的健脾作用,对霉菌炎症有一定的辅助改善作用。这样女性才能更好的保护自己的健康。
如何预防霉菌感染
1、定期检查
在生活中,可以通过定期体检来减少霉菌感染的机会。定期检查不仅能及时发现机体的异常病理反应,还能尽早发现潜在疾病,是预防霉菌感染的有效途径。
2、杜绝不洁性生活
为了预防霉菌感染的发生,希望你能杜绝生活中各种不洁的性行为,避免频繁更换性伴侣,不要频繁进行高危性行为。除此之外,你还应该注意在性生活中合理使用安全套,采取保护措施,这样才能有效降低霉菌感染的概率。
3、锻炼身体
白色念珠菌,主要是患者免疫力下降,会大量繁殖。因此,患者在预防霉菌性阴道炎时,最重要的是提高自身免疫力,积极参加体育锻炼,增加体质。同时要注意多摄取维生素和营养素,多吃新鲜蔬菜和水果,饮食均衡。
小结
霉菌性阴道炎的女性,平时可以多吃富含膳食纤维的食物,如黄瓜、茄子、绿豆、红薯、谷类等,可以帮助排出体内的有害物质。此外,还可以吃一些扁豆,有祛湿益气的作用,营养价值高,对治疗霉菌性阴道炎有帮助。

发表评论